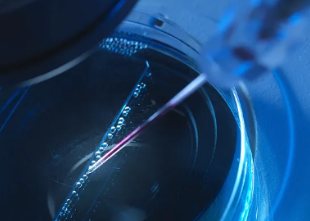
image.png

捐獻(xiàn)造血干細(xì)胞對(duì)人體影響大嗎?有哪些害處?
2024-10-29 15:23:13 來源: 小編 咨詢醫(yī)生
捐獻(xiàn)造血干細(xì)胞是一項(xiàng)拯救他人生命的高尚行為,對(duì)于許多患有血液病的人來說,它是重生的希望。然而,許多人對(duì)于捐獻(xiàn)造血干細(xì)胞是否會(huì)對(duì)人體造成影響存在疑慮,擔(dān)憂捐獻(xiàn)過程中可能帶來的害處。下面我們來了解一下捐獻(xiàn)造血干細(xì)胞對(duì)人體的影響以及可能存在的害處。
首先,我們需要明確的是,捐獻(xiàn)造血干細(xì)胞對(duì)人體的影響相對(duì)較小。在捐獻(xiàn)過程中,醫(yī)生會(huì)從捐**的骨髓或血液中提取干細(xì)胞。目前主要有兩種采集方式:一種是抽取骨髓,另一種是通過血液分離。對(duì)于抽取骨髓的捐**來說,手術(shù)通常在全身麻醉下進(jìn)行,捐**不會(huì)感受到疼痛。而對(duì)于通過血液分離的捐**,只需進(jìn)行靜脈穿刺,與獻(xiàn)血過程類似。
捐獻(xiàn)造血干細(xì)胞對(duì)人體的影響主要體現(xiàn)在以下幾個(gè)方面:
1.采集過程中可能出現(xiàn)的不良反應(yīng):部分捐**在采集過程中可能會(huì)出現(xiàn)頭暈、惡心、嘔吐等不適癥狀,這是因?yàn)樗幬锘虿杉^程中血管受到刺激導(dǎo)致的。這些癥狀在采集結(jié)束后會(huì)逐漸消失。
2.采集后身體恢復(fù):捐獻(xiàn)骨髓的捐**需要在醫(yī)院休息一段時(shí)間,等待傷口愈合。一般來說,傷口在1-2周內(nèi)可以恢復(fù)。捐獻(xiàn)血液分離的捐**,采集后只需注意休息和飲食,很快就能恢復(fù)正常。
3.長期影響:捐獻(xiàn)造血干細(xì)胞對(duì)捐**的長期影響非常小。部分捐**可能會(huì)在捐獻(xiàn)后出現(xiàn)輕微的疲勞感,但這種情況通常在數(shù)周內(nèi)消失。捐**不會(huì)因?yàn)榫璜I(xiàn)干細(xì)胞而影響自己的生活質(zhì)量和壽命。
至于捐獻(xiàn)造血干細(xì)胞的害處,實(shí)際上是非常罕見的。捐**在捐獻(xiàn)前都會(huì)接受嚴(yán)格的體檢,確保身體狀況良好。此外,醫(yī)生會(huì)在捐獻(xiàn)過程中密切監(jiān)測(cè)捐**的生命體征,確保安全。只要遵循醫(yī)生的建議,捐獻(xiàn)造血干細(xì)胞帶來的風(fēng)險(xiǎn)是非常低的。
總之,捐獻(xiàn)造血干細(xì)胞是一項(xiàng)充滿愛心的行為,對(duì)人體的影響較小,害處罕見。我們應(yīng)當(dāng)積極參與這項(xiàng)公益事業(yè),為那些需要幫助的人提供生命的希望。在了解捐獻(xiàn)過程和可能帶來的影響后,相信您會(huì)做出明智的選擇。
- 2024-09-27艾樂貝拉干細(xì)胞正什么功能
- 2024-08-26人脂肪干細(xì)胞功效,脂肪干細(xì)胞用途和作用
- 2024-11-04干細(xì)胞藥物最新研究進(jìn)展如何?
- 2024-09-13腎臟干細(xì)胞研究進(jìn)展,干細(xì)胞治療腎病的最新消息
- 2024-10-28干細(xì)胞轉(zhuǎn)精原細(xì)胞過程解析:成功率有多高?
- 2024-10-31捐造血干細(xì)胞有哪些流程和注意事項(xiàng)?
- 2024-08-28干細(xì)胞周身抗衰費(fèi)用與效果
- 2024-09-19造血干細(xì)胞移植后食譜,收好這份飲食指南
- 2024-09-21免疫nk干細(xì)胞療法是什么,你想知道的都在這
- 2024-09-27貝拉細(xì)胞醫(yī)院怎么樣
- 2024-09-03溫州牙髓干細(xì)胞功效是什么,牙髓干細(xì)胞的四大優(yōu)勢(shì)
- 2024-09-19胎盤干細(xì)胞存儲(chǔ)服務(wù),費(fèi)用是多少
- 2024-08-01臍帶血干細(xì)胞存儲(chǔ)量,臍帶血干細(xì)胞存儲(chǔ)多少錢一年
- 2024-09-18尿道干細(xì)胞修復(fù)費(fèi)用大概多少,修復(fù)原理和作用是什么
- 2024-10-11湖北牙髓干細(xì)胞有哪些作用?應(yīng)用范圍如何?
- 2024-08-19腫瘤干細(xì)胞療法的基礎(chǔ)研究和臨床應(yīng)用
- 2024-10-11吉利德公司在干細(xì)胞研究上有哪些突破?進(jìn)展如何?
- 2024-09-25干細(xì)胞再生研究進(jìn)展情況與發(fā)展趨勢(shì)
